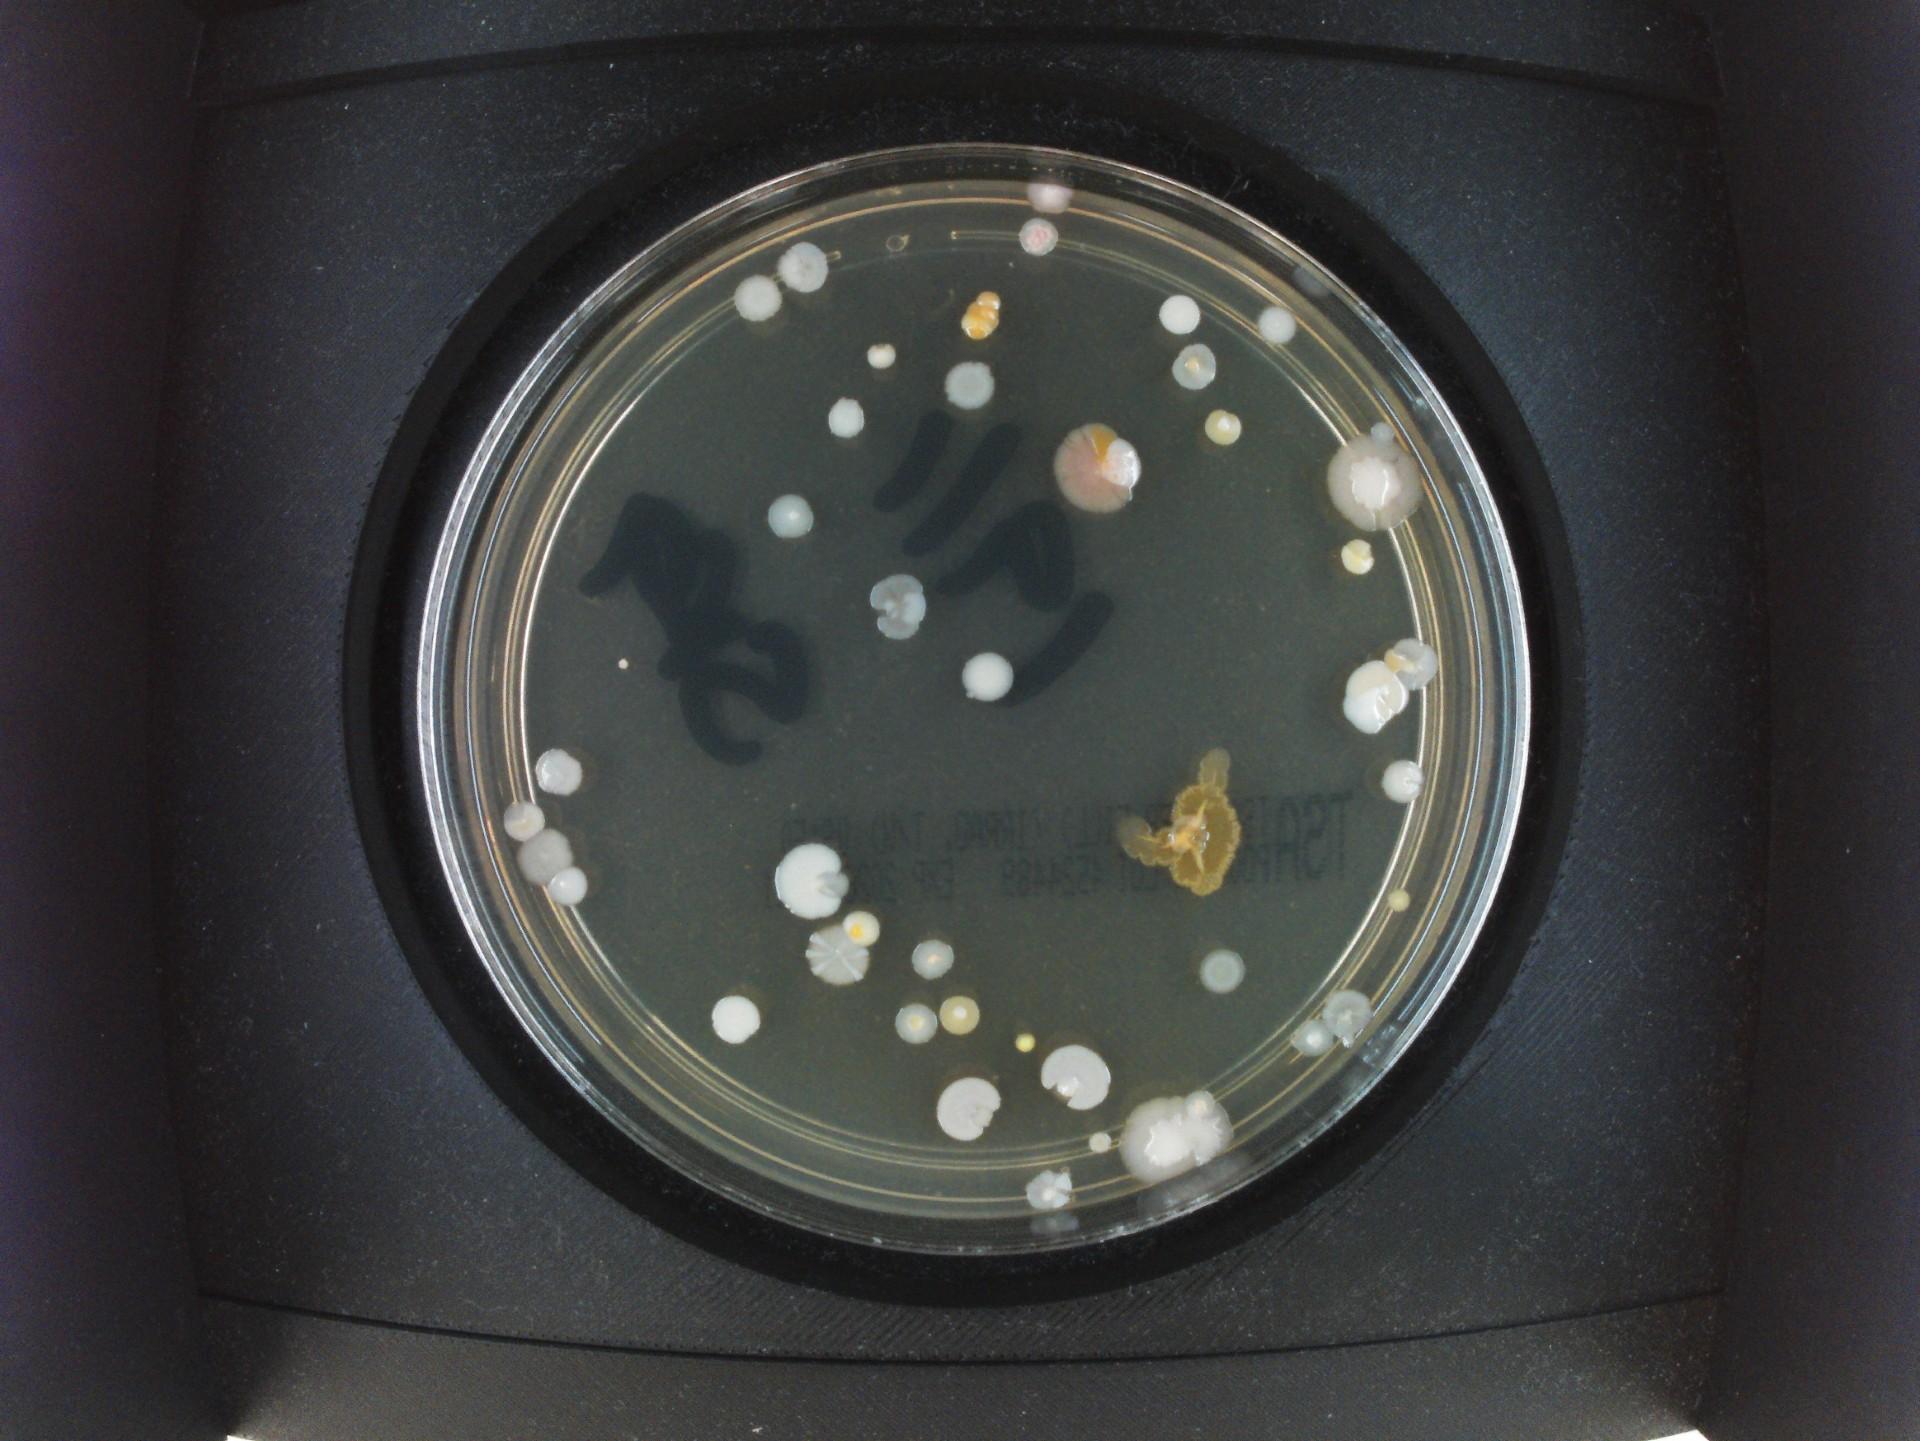
Petri dish with multiple small microbial colonies on agar, viewed from above.

Understanding Microbiology for Aseptic Services
- Start date: Future Dates TBC
- End date: Future Dates TBC
- Duration: One day course
- Fees: £TBC VAT Exempt
- Venue: Weetwood Hall Hotel, Leeds
enquire
The Understanding Microbiology for Aseptic Services course has been developed by NHS TSET (the Technical Specialist Education and Training group) and is facilitated by the University of Leeds.
For more information about TSET, visit their website.
A one-day course covering:
-
intelligent monitoring
-
interpretation of data
-
control measures
-
trending data
-
and investigations
Delivered via:
-
presentations
-
demonstrations
-
interactive discussions
-
and workshops
Important Information
If you work in a Trust where a bid for training funding requires a ‘case of need’, we recommend starting the request process early to avoid delays in securing your place.
This course has been specifically designed to give you an overview of practical microbiology and is ideal for those currently working in the aseptic services field. In particular accountable pharmacists should consider attending this course along with:
-
releasing officers
-
chief/senior technicians
-
authorised pharmacists
-
product approvers
-
and production managers
8.30am Registration and coffee
-
Welcome and Introduction
-
Intelligent monitoring
-
Microbes and their sources: how to best detect them and why they recur.
-
-
Interpretation of data – Workshop and Presentation
-
Reviewing and understanding micro results. Strange ids, no identification or genus id.
-
-
Workshop feedback
-
Trending data - Examples - how data can be used and assist decisions
-
Workshop – Investigations
-
Risk management of data, root cause analysis and CAPA; how best to react
-
-
Workshop feedback
-
Control measures
-
Contamination control strategies. Sanitisation and disinfection options, techniques and validation.
-
-
Guide to Cleanroom Microflora
-
Question and answers followed by course summary
4.30pm Close of course
Please note, CPD attendance certificates will be given out at the end of the course.
Please plan your travel to attend the full course, ensuring you stay through to the end to capture key takeaways and maximise your learning experience.
This one-day course will be delivered by experts in the NHS Pharmaceutical Microbiology field.
Course Director
Vikki Robbins, Senior Pharmaceutical Microbiologist, Liverpool University Hospitals NHS Foundation Trust
Speakers
Mark Oldcorne, Consultant QA Pharmacist
Vikki Robbins, Senior Pharmaceutical Microbiologist, Liverpool University Hospitals NHS Foundation Trust
Tim Sizer, Director of NHS TSET Healthcare CPD
Adam Walker, Head of Development and Innovation, NENC Provideer Collaborative Medicines Manufacturing Centre
James Walker, Assistant Head of Pharmacy–Production Services, Nottingham University Hospitals NHS Trust
Course fee: £TBC
Fees are VAT exempt
Course fee includes:
-
cost of tuition
-
course materials
-
lunch
-
light refreshments
View our terms and conditions
The course will take place at Weetwood Hall Hotel, which is situated to the north of Leeds at the junction of the A660 Leeds - Skipton road and the A6120 Outer Ring Road.
Weetwood Hall Hotel
Otley Road
Leeds
West Yorkshire
LS16 5PS
UK
Travel
International delegates travelling to the UK may need to apply for an Electronic Travel Authorisation (ETA). Be sure to apply in advance of your travel date. For further details, visit the UK government website.
Accommodation Information
If you require accommodation and wish to stay at the course venue, Weetwood Hall Hotel, please contact Stevie Standerline:
Email: reservations@weetwood.co.uk
Phone: 0113 230 6000
When booking, quote ‘CPD’ and the ‘Microbiology’ course.
Rates and Details:
Cost: £127 per night (bed and breakfast) VAT inclusive
Availability: Wednesday and/or Thursday evening
Room Type: Sole occupancy in a double room
Cancellation Policy: Free of charge up to 48 hours before arrival
Rooms are subject to availability, so early booking is recommended.
“Superb course, suitable for a range of staff groups that work in an aseptic or production field. The course was pitched at a good level. Started with a refresher to microorganisms and that got steadily more detailed as it went through the day.”
Jo Bramall, York & Scarborough Teaching Hospitals NHS Foundation Trust
“This course was excellent and helped me understand better how to investigate excursions.”
Seaneen McLaverty, Belfast Health and Social Care Trust
“Really useful, easy to understand course, a must for anyone working in Aseptic services.”
Cathy Samsudin, Mid Cheshire Hospitals NHS Foundation Trust
“Overall a very useful and comprehensive overview on microbiology contamination sources and control strategies. Good examples brought to the table and good update on Annex 1.”
Anne Lyttle , Belfast Health and Social Care Trust
Katie McCarthy – Course Coordinator
CPD Conference and Events Unit
Faculty of Engineering and Physical Sciences
University of Leeds
Leeds LS2 9JT
T: +44 (0)113 343 5746
Stay up to date with the latest course news and developments by following the CPD, Conference and Events unit on LinkedIn.



